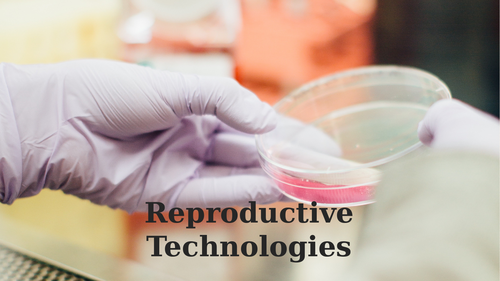
pptx, 20.92 MB

Includes :
- PowerPoint covering asexual reproduction in fungi, protists & bacteria with summary worksheet for students to complete
- PowerPoint covering sexual & asexual reproduction in plants with summary worksheet for students to complete on asexual reproduction methods
- Optional cut and paste sheets to complete above summaries (great for students who require extra support or who are just a little slower at writing!)
- Practical worksheet for flower dissection (including introduction on sexual reproduction in plants, and discussion questions)
- PowerPoint covering reproductive technologies with summary worksheet for students to complete
- Comprehension & graph interpretation worksheet covering hormone changes during pregnancy (including summary flow chart for students)
Something went wrong, please try again later.
This resource hasn't been reviewed yet
To ensure quality for our reviews, only customers who have purchased this resource can review it
Report this resourceto let us know if it violates our terms and conditions.
Our customer service team will review your report and will be in touch.
£10.00